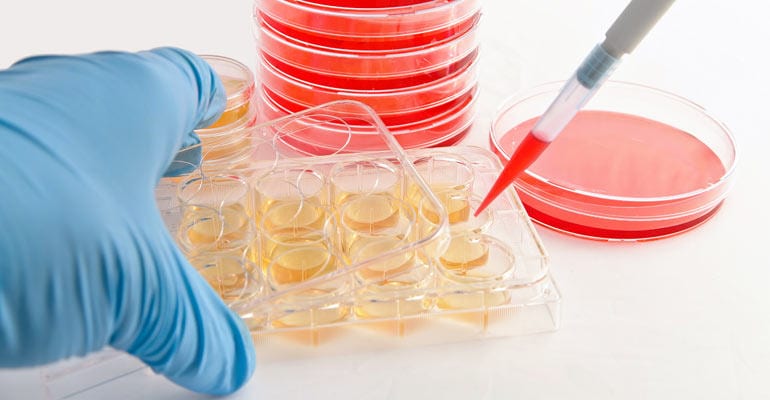
Enhancing Mesothelioma Research with Primary Cell Lines

Straight Talk About Mesothelioma, a blog series created by Michael T. Milano, M.D., Ph.D., a radiation oncology specialist, as a resource for mesothelioma patients and their loved ones.
Researchers in the United Kingdom recently published an important article that may change the way we study one of the world’s most difficult-to-treat cancers: malignant mesothelioma.
The researchers looked at different types of mesothelioma cell lines. They wanted to know how useful these cell lines were for studying the disease itself as well as for finding treatments.
What Are Cell Lines?
A cell line refers to a lineage of cells grown in the laboratory, with all cells being identical and derived from the same ancestor cell. With cancer cell lines, specific cancer cells are placed in a “culture dish” which provides the cells nutrients and an environment in which to grow and divide.
In cancer research, analyzing cells with the same genetic makeup allows researchers to better study a disease.
With cancer, cells divide and grow over time. When this is done in a laboratory, researchers can look at many things. They can see how fast or how slow cancer cells reproduce. They can see how a specific drug may kill harmful cells or stop them from growing.
When it comes to mesothelioma, they can see how tumors grow or how they respond to treatment.
Cell lines can also be used to implant tumors in mice (or other animals) to help better understand what happens when a tumor grows and divides in humans. This is important since the environment in a cell culture dish will not be the same as in an animal or person.
A Problem in Studying Mesothelioma Using Cell Lines
Cell lines that are developed in industrial laboratories are often sold to researchers for study. These are termed commercial cell lines. A commercial cell line from a single cell can result in many identical samples that are sold to researchers.
However, there may be differences between these cancer cells and the actual cancer cells that grow and spread in the human body. This is a potential problem in clinical research.
At this time, there is not a lot of research looking at how similar or different commercial cell lines are to cells in actual tumors. However, potential treatments are often initially studied using these cell lines in the laboratory.
So the question is, how can researchers be sure that treatments that were successful on a commercial cell line will also work when given to a human?
In other words, it is difficult to be sure a new cancer treatment will work until it is actually given to a human with mesothelioma.
Led by Dr. Tatyana Chernova, researchers from the UK wanted to look at this. They said that while studies using commercial cell lines are very important, successful translation into the clinical setting can be difficult.
As an example, they say that while there have been many promising new therapies studied using these cell lines, to date none have been approved for the treatment of mesothelioma. This means that studies using commercial cell lines in a laboratory may not always translate effectively into the real world.
This is a big challenge for researchers studying mesothelioma.
“Mesothelioma-derived cell lines provide an essential and relatively robust tool and remain among the most widely used systems for candidate drug evaluation.” – Chernova, MD
What Did the Researchers Do?
The question that the researchers asked was whether or not certain commercial mesothelioma cell lines look and act similarly to cancer cells taken directly from the body.
To do this they set up an experiment comparing 2 types of cells:
- Mesothelioma cells from commercial cell lines.
- Mesothelioma cells taken directly from tumors in patients. These are termed primary.
They compared many complex things between these 2 types of cells. They looked at physical appearance, how much and how fast the cells reproduced and functioned, and whether or not certain mesothelioma-related molecules and genes were there.
Basically, they wanted to see if cells from commercial cell lines were similar to cells from actual mesothelioma tumors. This is important because it would tell them how useful commercial cell lines are for developing treatments for actual mesothelioma tumors.
What Did the Researchers Find?
The researchers showed that:
- Cell lines derived directly from tumors (the primary cells) were more representative of the tumor itself.
- Cells from commercial and primary cell lines looked and operated differently. This includes the presence of certain molecules, rates of metabolism, and other mesothelioma-related factors.
So in short, the researchers found a lot of differences between commercial and primary cell lines. Most importantly, they found that the cells of commercial cell lines do not always match the tumor cells. This goes back to the problem above.
In their analysis, the authors state that “the key differences between primary and commercial malignant mesothelioma cell lines presented here highlight the importance of careful evaluation of a pre-clinical cellular model in terms of its suitability for a particular type of research.”
To summarize: researchers must be extremely careful in using commercial cell lines to draw conclusions about cells in the actual human body.
What Does All of This Mean?
The goal of cancer research is to study cells that are most similar to the tumors you are trying to treat. Then, the results of one’s research can be applied to the highest number of patients.
The researchers above suggest that a better idea might be to try to use more primary cell lines in research, rather than commercial cell lines. The study showed that primary cell lines are more representative of actual mesothelioma tumors.
Unfortunately, using primary cells takes a lot of time, energy, and money. However, this research sheds light on better ways of studying mesothelioma. The ultimate goal is to eventually translate it into better patient care.